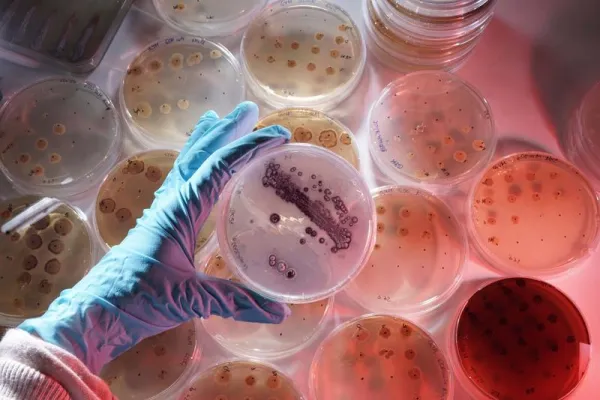
Mikroorganismen auf zwei Kontinenten studieren Bild: Mikroorganismen auf zwei Kontinenten studieren

(openPR) 16.02.2013 Werner Momsen im Lutterbeker
Dieser Liederabend wird die Bandbreite der Klassik neu definieren und egal was sie singen, Werner Momsen und Henning Kothe finden den richtigen Ton.
Werner Momsen, Hamburgs bekanntestes Klappmaul, will es diesmal nicht alleine tun und hat sich für seine Show einen Musiker gegönnt, der auf seiner Webseite verspricht, dass er selbst Klabautermänner zum Mitsingen bringt. Neben Momsens Geschichten soll es ein Liederabend durch Sturm, Heimat und Liebe werden. Wird es aber nicht. Denn dieser Musiker singt nicht stürmisch sondern klassisch. Schubert und Schumann statt Seefahrt und Shanty. Die Agentur hat’s vertauscht. Für Momsen eine Katastrophe, für die Zuschauer ein Spaß. Zwei Welten musikalischen Erlebens prallen aufeinander. Dieser Liederabend wird die Bandbreite der Klassik neu definieren und egal was sie singen, Werner Momsen und Henning Kothe finden den richtigen Ton. - Ein Abend mit Tenor und ganz speziellen Noten.
www.werner-momsen.de/meine-shows